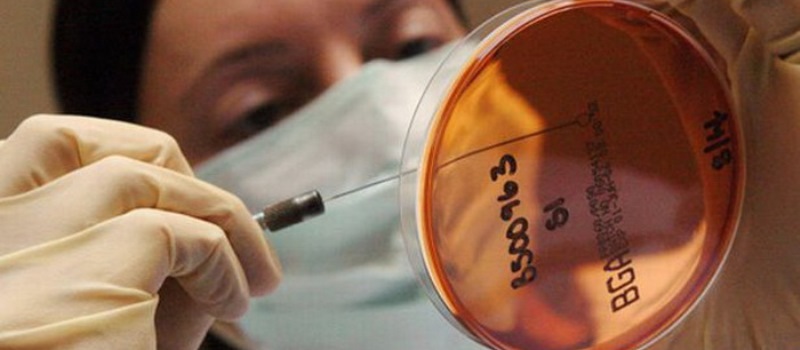

7 Animals That Can Live After Death
"220 000 pounds of poisoned dead fish scooped up in , These 7 Animals Survived What Dinosaurs Couldn't HuffPost, The 7 Most Dangerous Diseases: They Have No Symptoms But , 10 Most Lovable Animals That Can Become Gruesome Cannibals , Healing Loss : November 2012, I'm just so ready to give up and let myself fade into a , Motorists warned using mobile phones whilst driving can , Roses Are Red Baseball Uses a Bat According to All Known , SLO Pest and Termite Rats Rats are some of the most , ADAM AND EVE SEED GATHERING MINISTRY GO TO THE , Cayman Eco Beyond Cayman Peatland drainage in Southeast , Michael Jackson Windows 10 Theme themepack me, Established 1914 Ask Colonel ClearwaterDear Colonel , Table of Contents IslamicSupremacism org A Short Course , Unit 6 The Church Conquers the Empire During the reigns , ADAM AND EVE SEED GATHERING MINISTRY GO TO THE , Established 1914 GGGCHOOSE A MEMORABLE PASS WORD!A lady "